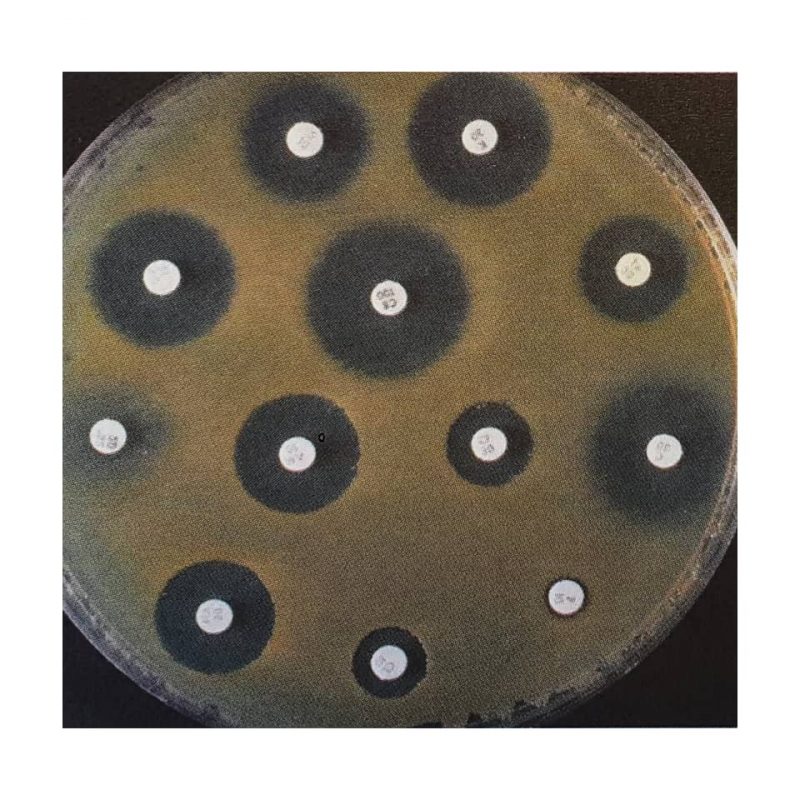

1 بهمن مصادف است با زادروز فردوسی شاعر حماسه سرای ایرانی، سرایندۀ شاهنامه، حماسۀ ملی ایران. در سال 319 هجری شمسی فرزندی در روستای پاژ از توابع طبران توس در خراسان دیده به جهان گشود. این کودک کسی نبود جز ابوالقاسم حسنپورعلی طوسی ملقب به استاد سخن حکیم توسی ابوالقاسم فردوسی. فردوسی دهقان و دهقانزاده […]
Category Archives: روز شمار فرهنگنامه
روز صادرات از سال ۱۳۷۶، ۲۹ مهرماه با تصویب شورای فرهنگ عمومی کشور به عنوان روز ملی صادرات انتخاب شد. هدف تعیین یک روز برای صادرات به ضمن ترویج فرهنگ صادرات در میان توده مردم از فعالان اقتصادی تقدیر می شود. پیدایش دولتها و تسخیر سرزمینهای دیگر، ساختن کشتی و استفاده از راههای آبی، […]
امروز ۱۳ شهریور مصادف است با روز بزرگداشت ابوریحان بیرونی ابوریحان بیرونی ( ۳۶۲-۴۴۰) هجری قمری میزیسته او هم دوره با ابو علی سینا بوده و بیشتر عمر خود را در دوره سلطان محمود غزنوی بوده او ریاضی دان ، اختر شناس ، جغرافی دان و پژوهشگر تاریخ بوده است از مهم ترین […]
به مناسب ۵ شهریور ماه روز داروسازی مقاله آنتی بیوتیک را برایتان انتخاب کردیم. آنتیبیوتیک ماده ای شیمیایی است که گروهی از قارچها با موجودات تک سلولی، آن را (یا ماده اصلی آن را) تولید می کنند و بر میکروبها (باکتریها و ویروسها) و قارچها اثر نابودکننده دارد. شمار زیادی از آنتیبیوتیکها بهطور مصنوعی ساخته […]
مردادماه روز جهانی مسجد است. برای همین ما مقاله ایاصوفیه را از جلد چهارم فرهنگنامه کودکان و نوجوانان برایتان انتخاب کردیم. اَیاصوفیه یکی از بناهای باستانی بزرگ جهان است که نخست کلیسا بود، بعدها به صورت مسجد درآمد، و امروز یکی از موزههای ترکیه در شهر استانبول است. در محلی که ایاصوفیه بنا شده است […]
28 مرداد مصادف است با روز جهانی عکاسی به همین منظور مقالۀ عکاسی را از جلد هجدهم فرهنگنامۀ کودکان و نوجوانان برایتان انتخاب کرده ایم. عَکاسی ثبت تصویر است به کمک دوربین عکاسی، نورهای بازتابشده از شیء پس از عبور از عدسی دستگاه عکسبرداری یا دوربین عکاسی، روی صفحه حساس به نور (فیلم یا سنسور […]